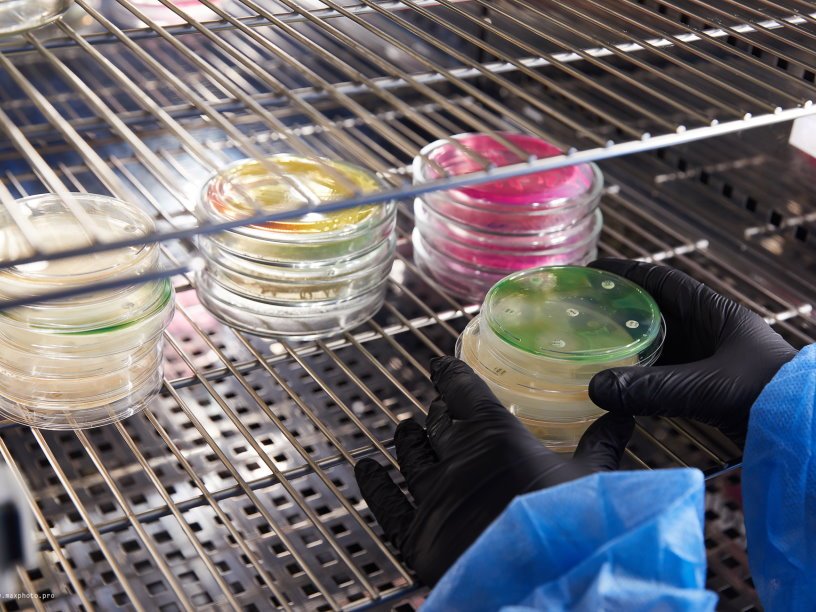

Антимикробные пептиды помогают антибиотикам
Ученые исследовали антимикробные пептиды человека, их количество, необходимое для уничтожения возбудителя болезни, и степень влияния на те или иные бактерии. На основе результатов была предложена новая стратегия борьбы с патогенными бактериями, устойчивыми к антибиотикам. Результаты исследования, проведенного при поддержке Президентской программы Российского научного фонда (РНФ), опубликованы в журнале PeerJ, кратко о них рассказывается на сайте РНФ.
По данным ВОЗ, устойчивость к антибиотикам — это одна из наиболее серьезных угроз для здоровья человечества, продовольственной безопасности и развития. Всё больше бактериальных инфекционных заболеваний — например, пневмонию, туберкулез, гонорею и сальмонеллез — становится труднее лечить из-за снижения эффективности антибиотиков. Один из видов противомикробных препаратов будущего — антимикробные пептиды, фрагменты белков, которые вырабатывают живые организмы для борьбы с инфекциями. Сотрудник Ставропольского государственного медицинского университета Альберт Болатчиев исследовал, как с микробами борются антимикробные пептиды из группы дефензинов, а именно HNP-1, hBD-1 и hBD-3. Они считаются наиболее перспективными, поскольку действуют на самые разные микроорганизмы (бактерии, вирусы, грибы).
Хотя дефензины уже изучались ранее, многое о них оставалось неизвестным. Например, какое минимальное количество вещества необходимо для уничтожения конкретного возбудителя — золотистого стафилококка или кишечной палочки, или какая фракционная концентрация необходима для борьбы с большим числом бактерий с разной степенью устойчивости к антибиотикам.
Противомикробное действие дефензинов автор статьи исследовал против 27 штаммов золотистого стафилококка и 24 штаммов кишечной палочки. Для того чтобы проверить «силу» антибактериального действия дефензинов (а также их комбинации с антибиотиками), использовали стандартный метод серийных разведений, так называемый метод «шахматной доски». Простота и удобство метода в том, что можно визуально наблюдать, какая концентрация вещества необходима для подавления роста бактериальных колоний. Кроме того, применение методики позволяет оценивать комбинированное противомикробное действие двух веществ на бактериальных возбудителей.
«Простота и удобство метода заключаются в том, что всё видно на глаз. Само исследование занимает 48 часов. Конечно, есть и свои сложности: нужно очень много разных бактериальных штаммов, то есть бактерий одного вида, но с разными свойствами и с разной чувствительностью к антибиотикам. Чем больше разных штаммов, тем выше точность эксперимента», — поясняет Альберт Болатчиев.
Удалось показать, что, если комбинировать антибактериальные препараты, например, рифампицин и амикацин, с дефензинами HNP-1 или hBD-3, можно снизить количество первых в несколько раз. Кроме того, выяснилось, что то, к каким именно антибиотикам устойчива конкретная бактерия (фенотип антибиотикорезистентности), никак не влияет на чувствительность изученных бактерий к антимикробным пептидам.
Сегодня еще много нерешенных вопросов, не позволяющих испытывать дефензины для лечения инфекций человека. «Во-первых, это очень дорогие молекулы. Во-вторых, они быстро разрушаются и их надо очень много. В-третьих, есть ограничения, связанные с их токсичностью в высоких дозах. Ученые рассматривают несколько решений этих задач. Так, можно вводить низкие дозы дефензинов в комбинации с обычными антибиотиками, что мы и показали. Кроме того, можно найти способы стимуляции синтеза собственных дефензинов — мы можем заставить наш организм вырабатывать больше пептидов. Также можно было бы разрабатывать новые — короткие и дешевые в производстве — модифицированные дефензины. Как раз в дальнейших исследованиях я планирую проверить данные предположения», — рассуждает Альберт Болатчиев.